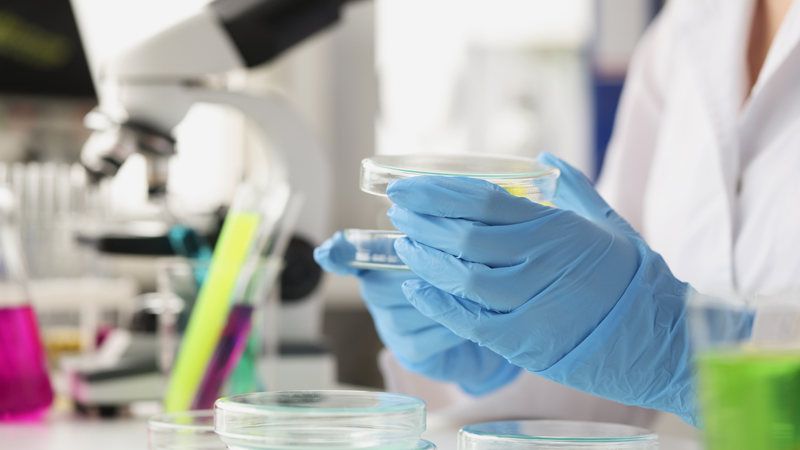
Vai trò của đậu nành trong việc cải thiện sức khỏe trao đổi chất 3

Tốt nghiệp Đại học Dược Hà Nội, với hơn 10 năm kinh nghiệm trong lĩnh vực Dược phẩm. Hiện là giảng viên giảng dạy các môn Dược lý, Dược lâm sàng,...
Cẩm Ly
26/08/2024
Mặc định
Lớn hơn
Đậu nành từ lâu đã được biết đến là một loại thực phẩm giàu dinh dưỡng, đặc biệt là protein thực vật. Những nghiên cứu gần đây đang nỗ lực để khám phá thêm một khía cạnh mới về lợi ích của loại đậu này đối với việc cải thiện quá trình trao đổi chất. Hãy cùng tìm hiểu về nghiên cứu liên quan đến vai trò của đậu nành trong việc cải thiện sức khỏe trao đổi chất trong bài viết dưới đây nhé!
Nghiên cứu mới của Tiến sĩ Candida Rebello tại Trung tâm Nghiên cứu Y sinh Pennington đang tiếp tục làm sáng tỏ tác động tích cực của đậu nành đối với sức khỏe, đặc biệt là về vai trò của đậu nành trong việc cải thiện sức khỏe trao đổi chất.
Nghiên cứu của bà mang tên "Can thiệp lối sống để cải thiện kết quả chuyển hóa và động lực" (MOTIVATE), tập trung vào việc khám phá mối liên hệ giữa lượng đường trong máu và chế độ ăn giàu đậu nành, đồng thời xem xét cách chế độ ăn uống và lối sống có thể ảnh hưởng đến tâm trạng và mức năng lượng.
Điểm đặc biệt của nghiên cứu này là việc sử dụng đậu nành cắt. Khi được cắt, hạt đậu nành giải phóng một hợp chất có tên là glyceollin, có khả năng cải thiện độ nhạy insulin và nhận thức. Đây được xem là một phát hiện quan trọng, mở ra cánh cửa cho những ứng dụng mới của đậu nành trong việc điều trị các bệnh liên quan đến chuyển hóa.

Về đối tượng nghiên cứu, nghiên cứu MOTIVATE dành cho người lớn từ 50 đến 75 tuổi, những người cảm thấy mức năng lượng thấp và có chỉ số khối cơ thể từ 30 trở lên. Nghiên cứu sẽ kéo dài khoảng 12 tuần và các người tham gia sẽ được cung cấp bữa ăn miễn phí.
Trong nghiên cứu, các tình nguyện viên sẽ được chia thành hai nhóm:
Trước khi chính thức tham gia nghiên cứu, tất cả các ứng viên tiềm năng đều phải trải qua một quá trình sàng lọc kỹ lưỡng để đảm bảo họ đáp ứng đầy đủ các tiêu chí.
Sau khi được chấp nhận vào nghiên cứu, các tình nguyện viên sẽ được cung cấp một chế độ ăn uống và tập luyện khoa học, được thiết kế riêng để phù hợp với mục tiêu của nghiên cứu. Cụ thể, họ sẽ đến trung tâm nghiên cứu ba lần một tuần để tham gia các buổi tập luyện và nhận bữa ăn.
Các chỉ số sức khỏe như tiền sử bệnh án, chiều cao, cân nặng, độ nhạy insulin, điện tâm đồ và xét nghiệm mật độ xương sẽ được theo dõi. Những người tham gia cũng sẽ nhận được khoản tiền lên tới 660 đô la cho sự tham gia của họ.

Như đã đề cập ở phần trên, một điểm đặc biệt của nghiên cứu này là việc chia các tình nguyện viên thành hai nhóm: Một nhóm sẽ được cung cấp chế độ ăn giàu đậu nành, trong khi nhóm còn lại sẽ có chế độ ăn không chứa đậu nành. Việc so sánh kết quả giữa hai nhóm sẽ giúp các nhà khoa học đánh giá chính xác tác động của đậu nành lên sức khỏe.
Bên cạnh nghiên cứu trên, những nghiên cứu trước về đậu nành cũng đã chỉ ra nhiều lợi ích cho sức khỏe trao đổi chất. Ví dụ, một nghiên cứu đăng trên Journal of Diabetes Research đã cho thấy protein đậu nành có khả năng cải thiện độ nhạy insulin và điều chỉnh lượng đường trong máu. Nghiên cứu khác, được công bố trong American Journal of Clinical Nutrition, xác nhận rằng tiêu thụ đậu nành có thể giảm cholesterol LDL và triglycerides, giảm nguy cơ bệnh tim mạch.
Hơn nữa, một bài báo trong Nutrition Reviews chỉ ra rằng đậu nành có thể giúp giảm chỉ số khối cơ thể và cải thiện các chỉ số sức khỏe trao đổi chất ở những người thừa cân và béo phì. Những nghiên cứu này cung cấp bằng chứng rõ ràng về tác động tích cực của đậu nành đối với sức khỏe trao đổi chất.

Như vậy, bài viết trên đã giúp bạn có cái nhìn tổng quan về vai trò của đậu nành trong việc cải thiện sức khỏe trao đổi chất. Những nghiên cứu hiện tại cho thấy đậu nành có thể có tác động tích cực đến lượng đường trong máu, cholesterol và chỉ số khối cơ thể. Tuy nhiên, vẫn cần nhiều nghiên cứu thêm để xác nhận và làm rõ hơn các lợi ích này, cũng như để hiểu rõ hơn về cơ chế và hiệu quả lâu dài của đậu nành đối với sức khỏe trao đổi chất.
Dược sĩ Đại họcNguyễn Thanh Hải
Tốt nghiệp Đại học Dược Hà Nội, với hơn 10 năm kinh nghiệm trong lĩnh vực Dược phẩm. Hiện là giảng viên giảng dạy các môn Dược lý, Dược lâm sàng,...